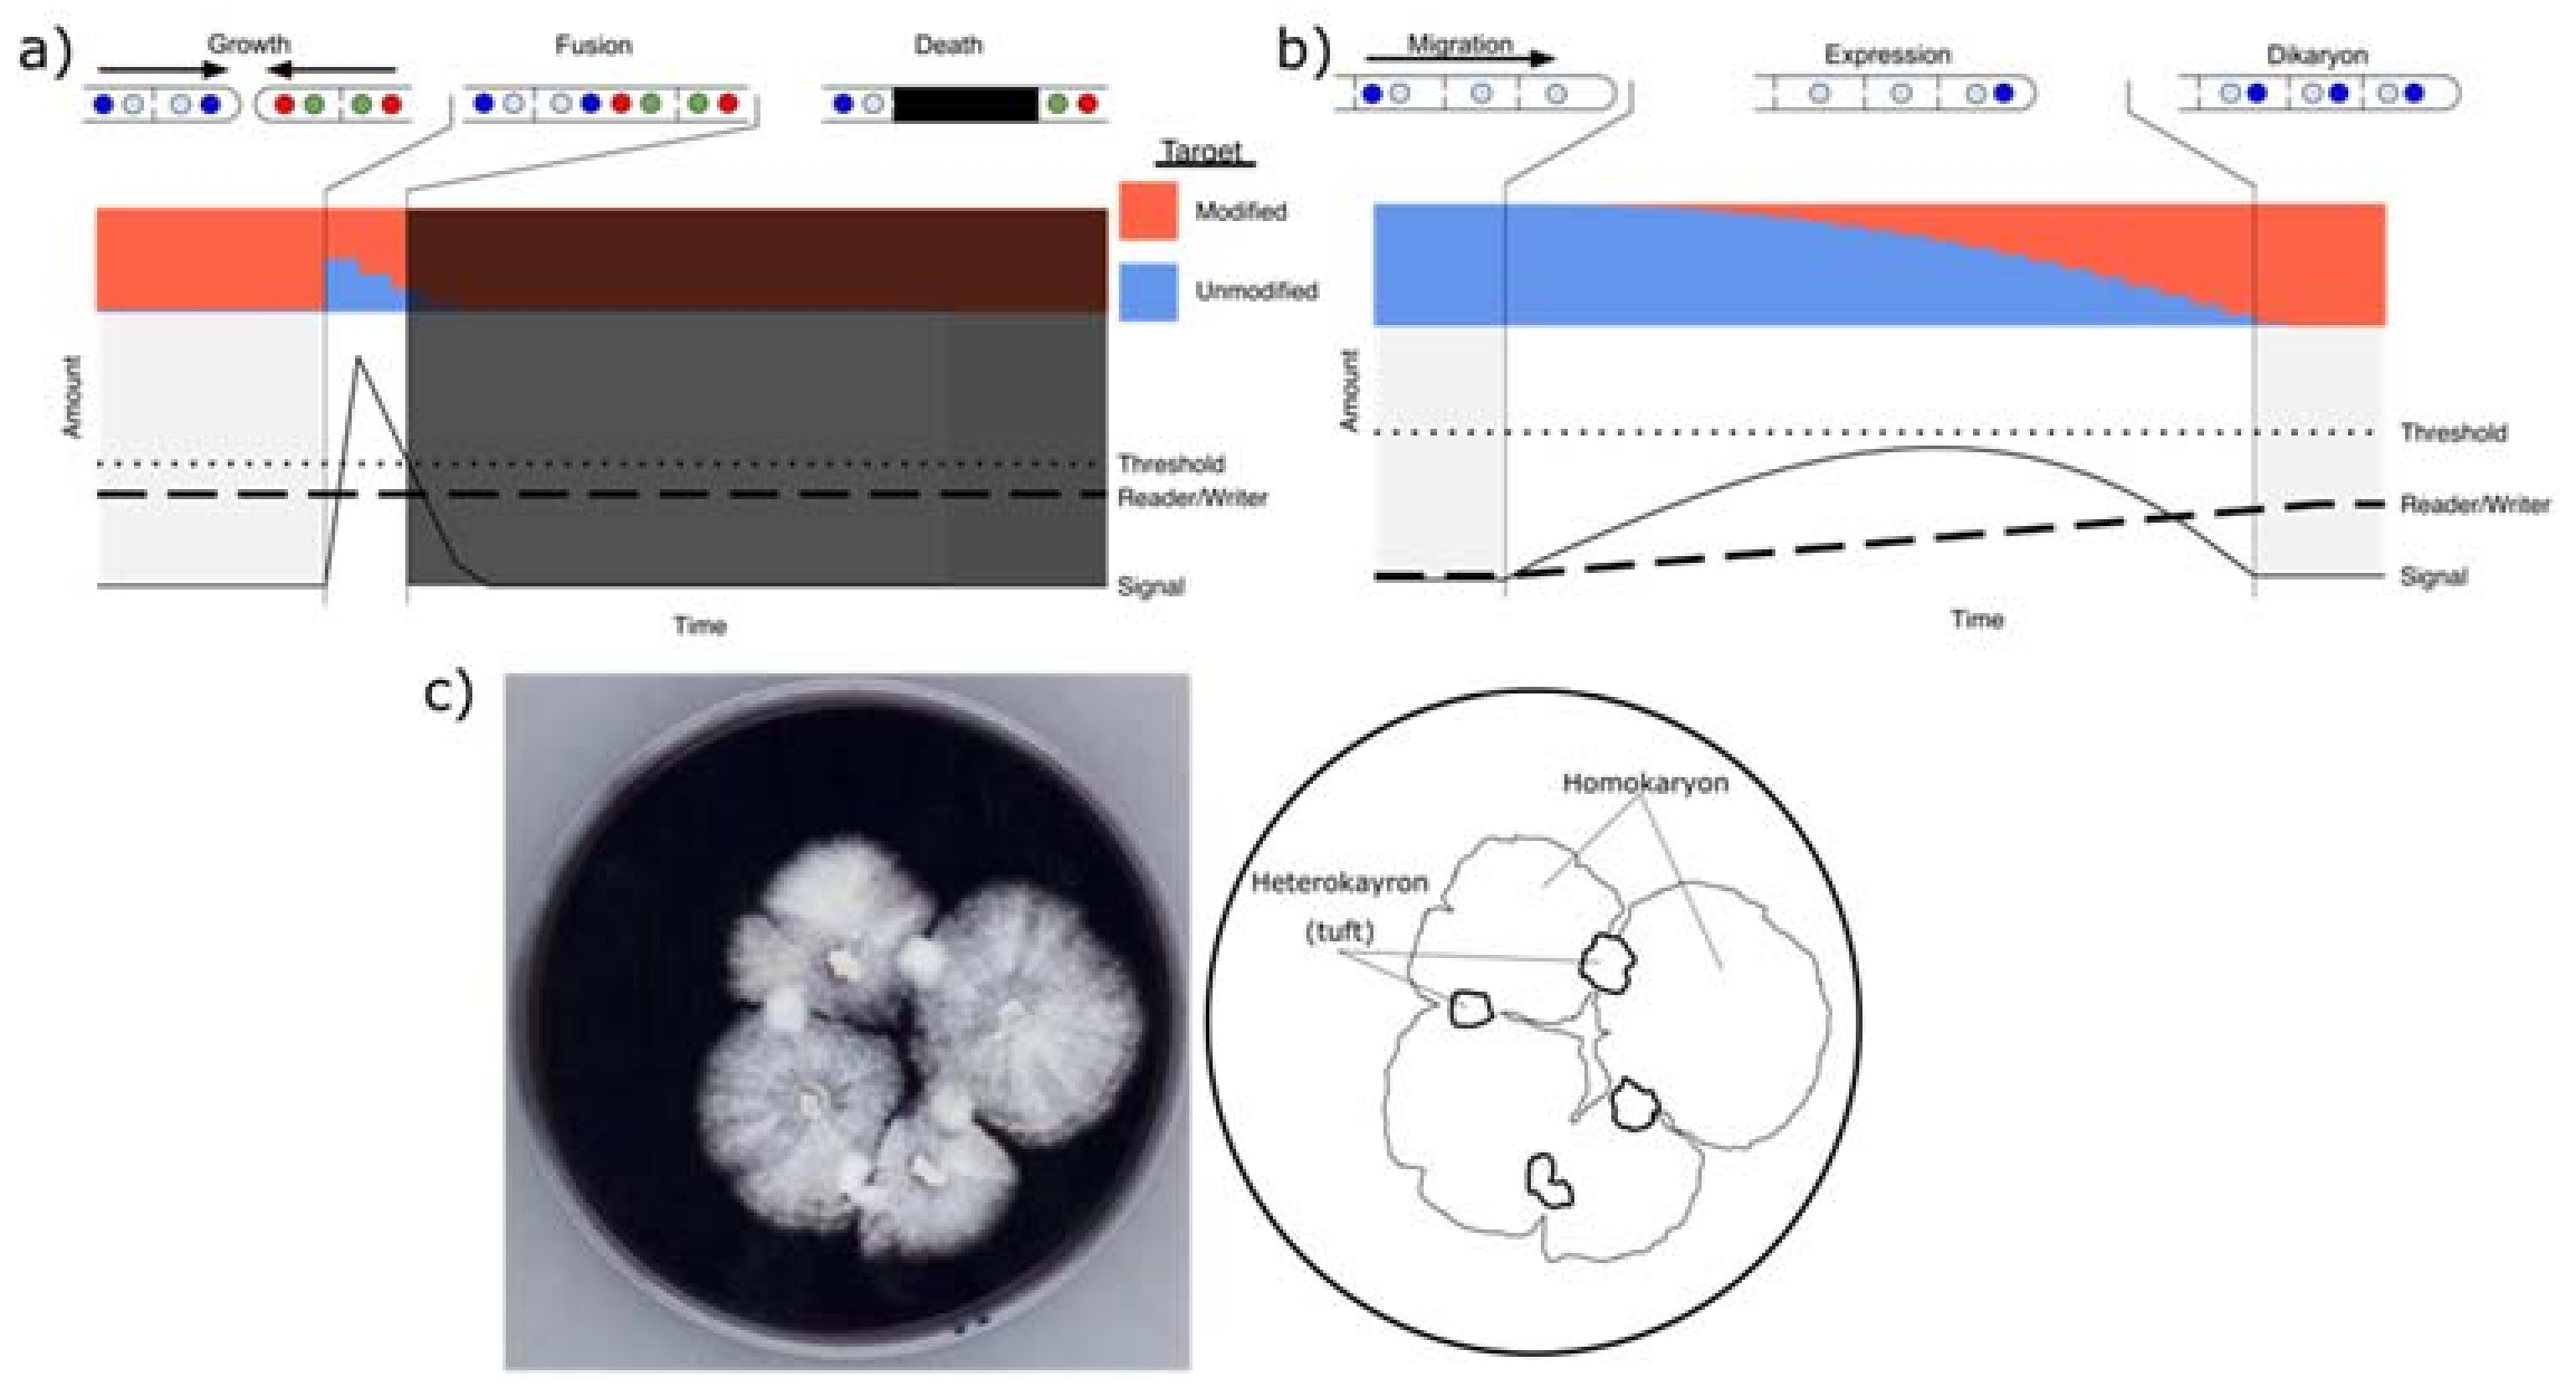

Cytoplasmic Mixing, Not Nuclear Coexistence, Can Explain Somatic Incompatibility in Basidiomycetes
Abstract
1. Introduction
2. Genetics and Principles of Ascomycete SI
3. Differences between Ascomycete and Basidiomycete Species Regarding Nonself Recognition
4. Dikaryotic Ascomycete Fungi May Serve as a Guide to Understand Basidiomycete SI
5. Outcomes of Traditional Models of Nonself Recognition
5.1. Sexual Compatibility Only When Somatic Compatibility Is Excluded (Allelic/Nonallelic Interactions)
5.2. Differential Expression
5.3. Post-Translational Modification
5.4. Differential Expression of a Post-Translation Modification System
6. A Basidiomycete Scenario
7. Genetics of Proposed Model
8. Conclusions
Author Contributions
Funding
Institutional Review Board Statement
Informed Consent Statement
Data Availability Statement
Acknowledgments
Conflicts of Interest
References
- Bastiaans, E.; Debets, A.J.M.; Aanen, D.K. Experimental Demonstration of the Benefits of Somatic Fusion and the Consequences for Allorecognition. Evolution 2015, 69, 1091–1099. [Google Scholar] [CrossRef]
- Anagnostakis, S.L. Conversion to Curative Morphology in Endothia parasitica and Its Restriction by Vegetative Compatibility. Mycologia 1983, 75, 777–780. [Google Scholar] [CrossRef]
- Czárán, T.; Hoekstra, R.F.; Aanen, D.K. Selection against Somatic Parasitism Can Maintain Allorecognition in Fungi. Fungal Genet. Biol. 2014, 73, 128–137. [Google Scholar] [CrossRef]
- Debets, A.J.M.; Yang, X.; Griffiths, A.J.F. Vegetative Incompatibility in Neurospora: Its Effect on Horizontal Transfer of Mitochondrial Plasmids and Senescence in Natural Populations. Curr. Genet. 1994, 26, 113–119. [Google Scholar] [CrossRef] [PubMed]
- Grum-Grzhimaylo, A.A.; Bastiaans, E.; van den Heuvel, J.; Berenguer Millanes, C.; Debets, A.J.M.; Aanen, D.K. Somatic Deficiency Causes Reproductive Parasitism in a Fungus. Nat. Commun. 2021, 12, 783. [Google Scholar] [CrossRef]
- Uehling, J.; Deveau, A.; Paoletti, M. Do Fungi Have an Innate Immune Response? An NLR-Based Comparison to Plant and Animal Immune Systems. PLoS Pathog. 2017, 13, e1006578. [Google Scholar] [CrossRef] [PubMed]
- Medzhitov, R.; Janeway, C.A. Decoding the Patterns of Self and Nonself by the Innate Immune System. Science 2002, 296, 298–300. [Google Scholar] [CrossRef] [PubMed]
- Murray, N.E. Immigration Control of DNA in Bacteria: Self versus Non-Self. Microbiology 2002, 148, 3–20. [Google Scholar] [CrossRef]
- Gordeeva, J.; Morozova, N.; Sierro, N.; Isaev, A.; Sinkunas, T.; Tsvetkova, K.; Matlashov, M.; Truncaitė, L.; Morgan, R.D.; Ivanov, N.V.; et al. BREX System of Escherichia coli Distinguishes Self from Non-Self by Methylation of a Specific DNA Site. Nucleic Acids Res. 2019, 47, 253–265. [Google Scholar] [CrossRef] [PubMed]
- Pleška, M.; Qian, L.; Okura, R.; Bergmiller, T.; Wakamoto, Y.; Kussell, E.; Guet, C.C. Bacterial Autoimmunity Due to a Restriction-Modification System. Curr. Biol. 2016, 26, 404–409. [Google Scholar] [CrossRef]
- Worrall, J.J. Somatic Incompatibility in Basidiomycetes. Mycologia 1997, 89, 24–36. [Google Scholar] [CrossRef]
- Sahashi, N.; Akiba, M.; Ishihara, M.; Miyazaki, K.; Seki, S. Distribution of Genets of Cylindrobasidium argenteum in a River Valley Forest as Determined by Somatic Incompatibility, and the Significance of Basidiospores for Its Dispersal. Mycol. Prog. 2010, 9, 425–429. [Google Scholar] [CrossRef]
- Stenlid, J. Population Structure of Heterobasidion annosum as Determined by Somatic Incompatibility, Sexual Incompatibility, and Isoenzyme Patterns. Can. J. Bot. 1985, 63, 2268–2273. [Google Scholar] [CrossRef]
- Travadon, R.; Smith, M.E.; Fujiyoshi, P.; Douhan, G.W.; Rizzo, D.M.; Baumgartner, K. Inferring Dispersal Patterns of the Generalist Root Fungus Armillaria mellea. New Phytol. 2012, 193, 959–969. [Google Scholar] [CrossRef]
- May, G. Somatic Incompatibility and Individualism in the Coprophilous Basidiomycete, Coprinus cinereus. Trans. Br. Mycol. Soc. 1988, 91, 443–451. [Google Scholar] [CrossRef]
- Hansen, E.M.; Stenlid, J.; Johansson, M. Genetic Control of Somatic Incompatibility in the Root-Rotting Basidiomycete Heterobasidion annosum. Mycol. Res. 1993, 97, 1229–1233. [Google Scholar] [CrossRef]
- Kauserud, H.; Schmidt, O.; Elfstrand, M.; Högberg, N. Extremely Low AFLP Variation in the European Dry Rot Fungus (Serpula lacrymans): Implications for Self/Nonself-Recognition. Mycol. Res. 2004, 108, 1264–1270. [Google Scholar] [CrossRef]
- Lind, M.; Stenlid, J.; Olson, Å. Genetics and QTL Mapping of Somatic Incompatibility and Intraspecific Interactions in the Basidiomycete Heterobasidion annosum s.l. Fungal Genet. Biol. 2007, 44, 1242–1251. [Google Scholar] [CrossRef] [PubMed]
- Rizzo, D.M.; Rentmeester, R.M.; Burdsall, H.H., Jr. Sexuality and Somatic Incompatibility in Phellinus gilvus. Mycologia 1995, 87, 805–820. [Google Scholar] [CrossRef]
- van der Nest, M.A.; Slippers, B.; Steenkamp, E.T.; De Vos, L.; Van Zyl, K.; Stenlid, J.; Wingfield, M.J.; Wingfield, B.D. Genetic Linkage Map for Amylostereum areolatum Reveals an Association between Vegetative Growth and Sexual and Self-Recognition. Fungal Genet. Biol. 2009, 46, 632–641. [Google Scholar] [CrossRef] [PubMed][Green Version]
- Glass, N.L.; Dementhon, K. Non-Self Recognition and Programmed Cell Death in Filamentous Fungi. Curr. Opin. Microbiol. 2006, 9, 553–558. [Google Scholar] [CrossRef]
- Daskalov, A.; Mitchell, P.S.; Sandstrom, A.; Vance, R.E.; Glass, N.L. Molecular Characterization of a Fungal Gasdermin-like Protein. Proc. Natl. Acad. Sci. USA 2020, 117, 18600–18607. [Google Scholar] [CrossRef] [PubMed]
- Daskalov, A.; Gladieux, P.; Heller, J.; Glass, N.L. Programmed Cell Death in Neurospora crassa Is Controlled by the Allorecognition Determinant rcd-1. Genetics 2019, 213, 1387–1400. [Google Scholar] [CrossRef]
- Nauta, M.J.; Hoekstra, R.F. Evolution of Vegetative Incompatibility in Filamentous Ascomycetes. I. Deterministic Models. Evolution 1994, 48, 979–995. [Google Scholar] [CrossRef]
- Newmeyer, D. A Suppreson of the Heterokaryon- Incompatibility Associated with Mating Type in Neurospora crassa. Can. J. Genet. Cytol. 2011. [Google Scholar] [CrossRef]
- Shiu, P.K.T.; Glass, N.L. Molecular Characterization of tol, a Mediator of Mating-Type-Associated Vegetative Incompatibility in Neurospora crassa. Genetics 1999, 151, 545–555. [Google Scholar] [CrossRef] [PubMed]
- Heller, J.; Clavé, C.; Gladieux, P.; Saupe, S.J.; Glass, N.L. NLR Surveillance of Essential SEC-9 SNARE Proteins Induces Programmed Cell Death upon Allorecognition in Filamentous Fungi. Proc. Natl. Acad. Sci. USA 2018, 115, E2292–E2301. [Google Scholar] [CrossRef]
- Hedrick, P.W.; Thomson, G. Evidence for Balancing Selection at HLA. Genetics 1983, 104, 449–456. [Google Scholar] [CrossRef]
- Milgroom, M.G.; Smith, M.L.; Drott, M.T.; Nuss, D.L. Balancing Selection at Nonself Recognition Loci in the Chestnut Blight Fungus, Cryphonectria parasitica, Demonstrated by Trans-Species Polymorphisms, Positive Selection, and Even Allele Frequencies. Heredity 2018, 121, 511–523. [Google Scholar] [CrossRef] [PubMed]
- Wu, J.; Saupe, S.J.; Glass, N.L. Evidence for Balancing Selection Operating at the het-c Heterokaryon Incompatibility Locus in a Group of Filamentous Fungi. Proc. Natl. Acad. Sci. USA 1998, 95, 12398–12403. [Google Scholar] [CrossRef] [PubMed]
- Zhao, J.; Gladieux, P.; Hutchison, E.; Bueche, J.; Hall, C.; Perraudeau, F.; Glass, N.L. Identification of Allorecognition Loci in Neurospora crassa by Genomics and Evolutionary Approaches. Mol. Biol. Evol. 2015, 32, 2417–2432. [Google Scholar] [CrossRef] [PubMed]
- Debets, A.J.M.; Dalstra, H.J.P.; Slakhorst, M.; Koopmanschap, B.; Hoekstra, R.F.; Saupe, S.J. High Natural Prevalence of a Fungal Prion. Proc. Natl. Acad. Sci. USA 2012, 109, 10432–10437. [Google Scholar] [CrossRef]
- Grafen, A. Do Animals Really Recognize Kin? Anim. Behav. 1990, 39, 42–54. [Google Scholar] [CrossRef]
- Paoletti, M.; Saupe, S.J. Fungal Incompatibility: Evolutionary Origin in Pathogen Defense? BioEssays 2009, 31, 1201–1210. [Google Scholar] [CrossRef]
- Aanen, D.K.; Debets, A.J.M.; de Visser, J.A.G.M.; Hoekstra, R.F. The Social Evolution of Somatic Fusion. BioEssays 2008, 30, 1193–1203. [Google Scholar] [CrossRef] [PubMed]
- Rousset, F.; Roze, D. Constraints on the Origin and Maintenance of Genetic Kin Recognition. Evolution 2007, 61, 2320–2330. [Google Scholar] [CrossRef]
- Paoletti, M. Vegetative Incompatibility in Fungi: From Recognition to Cell Death, Whatever Does the Trick. Fungal Biol. Rev. 2016, 30, 152–162. [Google Scholar] [CrossRef]
- Van der Nest, M.A.; Olson, Å.; Lind, M.; Vélëz, H.; Dalman, K.; Durling, M.B.; Karlsson, M.; Stenlid, J. Distribution and Evolution of het Gene Homologs in the Basidiomycota. Fungal Genet. Biol. 2014, 64, 45–57. [Google Scholar] [CrossRef]
- Brown, A.J.; Casselton, L.A. Mating in Mushrooms: Increasing the Chances but Prolonging the Affair. Trends Genet. 2001, 17, 393–400. [Google Scholar] [CrossRef]
- James, T. Why Mushrooms Have Evolved to Be so Promiscuous: Insights from Evolutionary and Ecological Patterns. Fungal Biol. Rev. 2015, 29, 167–178. [Google Scholar] [CrossRef]
- Kämper, J.; Friedrich, M.W.; Kahmann, R. Creating Novel Specificities in a Fungal Nonself Recognition System by Single Step Homologous Recombination Events. New Phytol. 2020, 228, 1001–1010. [Google Scholar] [CrossRef]
- Aanen, D.K.; Kuyper, T.W.; Debets, A.J.M.; Hoekstra, R.F. The Evolution of Non–Reciprocal Nuclear Exchange in Mushrooms as a Consequence of Genomic Conflict. Proc. R. Soc. Lond. B Biol. Sci. 2004, 271, 1235–1241. [Google Scholar] [CrossRef]
- Ainsworth, A.M.; Rayner, A.D.M. Responses of Living Hyphae Associated with Self and Non-Self Fusions in the Basidiomycete Phanerochaete velutina. Microbiology 1986, 132, 191–201. [Google Scholar] [CrossRef][Green Version]
- Julián, M.; Debets, F.; Keijer, J. Independance of Sexual and Vegetative Incompatibility Mechanisms of Thanatephorus cucumeris (Rhizoctonia solani) Anastamosis Group I. Phytopathology 1996, 86, 566–574. [Google Scholar] [CrossRef]
- Qu, P.; Saldajeno, M.G.B.; Hyakumachi, M. Mechanism of the Generation of New Somatic Compatibility Groups within Thanatephorus cucumeris (Rhizoctonia solani). Microbes Environ. 2013, 28, 325–335. [Google Scholar] [CrossRef]
- Rayner, A.D.M. The Challenge of the Individualistic Mycelium. Mycologia 1991, 83, 48–71. [Google Scholar] [CrossRef]
- Casselton, L.A.; Condit, A. A Mitochondrial Mutant of Coprinus lagopus. Microbiology 1972, 72, 521–527. [Google Scholar] [CrossRef][Green Version]
- Bruggeman, J.; Debets, A.J.M.; Swart, K.; Hoekstra, R.F. Male and Female Roles in Crosses of Aspergillus nidulans as Revealed by Vegetatively Incompatible Parents. Fungal Genet. Biol. 2003, 39, 136–141. [Google Scholar] [CrossRef]
- Troppens, D.M.; Köhler, A.M.; Schlüter, R.; Hoppert, M.; Gerke, J.; Braus, G.H. Hülle Cells of Aspergillus nidulans with Nuclear Storage and Developmental Backup Functions Are Reminiscent of Multipotent Stem Cells. mBio 2020, 11, e01673-20. [Google Scholar] [CrossRef]
- Buller, A. Researches on Fungi; Longmans, Green and Company: London, UK, 1930; Volume 4. [Google Scholar]
- Quintanilha, A. Contribution a l’étude Génétique Du Phenomene de Buller. C. R. Acad. Sci. Paris 1937, 205, 745. [Google Scholar]
- Nieuwenhuis, B.P.S.; Nieuwhof, S.; Aanen, D.K. On the Asymmetry of Mating in Natural Populations of the Mushroom Fungus Schizophyllum commune. Fungal Genet. Biol. 2013, 56, 25–32. [Google Scholar] [CrossRef] [PubMed]
- Jacobson, D.J. Control of Mating Type Heterokaryon Incompatibility by the tol Gene in Neurospora crassa and N. tetrasperma. Genome 1992, 35, 347–353. [Google Scholar] [CrossRef]
- Saenz, G.S.; Stam, J.G.; Jacobson, D.J.; Natvig, D.O. Heteroallelism at the het-c Locus Contributes to Sexual Dysfunction in Outcrossed Strains of Neurospora tetrasperma. Fungal Genet. Biol. 2001, 34, 123–129. [Google Scholar] [CrossRef][Green Version]
- Jacobson, D.J. Sexual Dysfunction Associated with Outcrossing in Neurospora tetrasperma, a Pseudohomothallic Ascomycete. Mycologia 1995, 87, 604–617. [Google Scholar] [CrossRef]
- Powell, A.J.; Jacobson, D.J.; Natvig, D.O. Allelic Diversity at the het-c Locus in Neurospora tetrasperma Confirms Outcrossing in Nature and Reveals an Evolutionary Dilemma for Pseudohomothallic Ascomycetes. J. Mol. Evol. 2001, 52, 94–102. [Google Scholar] [CrossRef] [PubMed]
- Saupe, S.J. The [Het-s] Prion of Podospora anserina and Its Role in Heterokaryon Incompatibility. Semin. Cell Dev. Biol. 2011, 22, 460–468. [Google Scholar] [CrossRef] [PubMed]
- Saupe, S.J.; Daskalov, A. The [Het-s] Prion, an Amyloid Fold as a Cell Death Activation Trigger. PLoS Pathog. 2012, 8, e1002687. [Google Scholar] [CrossRef]
- Bernet, J. Mode d’action Des Génes de “Barrage” et Relation Entre l’incompatibilité Cellulaire et l’incompatibilité Sexuelle Chez Le Podospora Anserina. Ann. Sci. Nat. Bot. 1965, 6, 611–768. [Google Scholar]
- Saupe, S.J. A Short History of Small s. Prion 2007, 1, 110–115. [Google Scholar] [CrossRef][Green Version]
- Ament-Velásquez, S.L. Drivers of Evolutionary Change in Podospora anserina. Ph.D. Thesis, Uppsala University, Uppsala, Sweden, 2020. [Google Scholar]
- Labarère, J.; Bégueret, J.; Bernet, J. Incompatibility in Podospora anserina: Comparative Properties of the Antagonistic Cytoplasmic Factors of a Nonallelic System. J. Bacteriol. 1974, 120, 854–860. [Google Scholar] [CrossRef] [PubMed]
- Labarère, J.; Bernet, J. Protoplasmic Incompatibility and Cell Lysis in Podospora Anserina. I. Genetic Investigations on Mutations of a Novel Modifier Gene That Suppresses Cell Destruction. Genetics 1977, 87, 249–257. [Google Scholar] [CrossRef] [PubMed]
- Cheng, E.H.-Y.; Kirsch, D.G.; Clem, R.J.; Ravi, R.; Kastan, M.B.; Bedi, A.; Ueno, K.; Hardwick, J.M. Conversion of Bcl-2 to a Bax-like Death Effector by Caspases. Science 1997, 278, 1966–1968. [Google Scholar] [CrossRef]
- MacLachlan, T.K.; El-Deiry, W.S. Apoptotic Threshold Is Lowered by P53 Transactivation of Caspase-6. Proc. Natl. Acad. Sci. USA 2002, 99, 9492–9497. [Google Scholar] [CrossRef]
- Ainsworth, A.M.; Rayner, A.D.M. Hyphal and Mycelial Responses Associated with Genetic Exchange Within and Between Species of the Basidiomycete Genus Stereum. Microbiology 1989, 135, 1643–1659. [Google Scholar] [CrossRef]
- Swiezynski, K.; Day, P. Heterokaryon Formation in Coprinus lagopus. Genet. Res. 1960, 1, 114–128. [Google Scholar] [CrossRef]
- Jacobson, K.M.; Miller, O.K.; Turner, B.J. Randomly Amplified Polymorphic DNA Markers Are Superior to Somatic Incompatibility Tests for Discriminating Genotypes in Natural Populations of the Ectomycorrhizal Fungus Suillus granulatus. Proc. Natl. Acad. Sci. USA 1993, 90, 9159–9163. [Google Scholar] [CrossRef]
- Todd, N.K.; Rayner, A.D.M. Genetic Structure of a Natural Population of Coriolus versicolor (L. Ex Fr.) Quél. Genet. Res. 1978, 32, 55–65. [Google Scholar] [CrossRef]
- Marcais, B.; Caël, O.; Delatour, C. Genetics of Somatic Incompatibility in Collybia fusipes. Mycol. Res. 2000, 104, 304–310. [Google Scholar] [CrossRef][Green Version]

| A1/A1 | A1/A2 | A2/A1 | A2/A2 | |
|---|---|---|---|---|
| A1/A1 | C | |||
| A1/A2 | C | C | ||
| A2/A1 | C | C | ||
| A2/A2 | C |
| A1/A1 | A1/A2 | A1/A3 | A2/A1 | A2/A2 | A2/A3 | A3/A1 | A3/A2 | A3/A3 | |
|---|---|---|---|---|---|---|---|---|---|
| A1/A1 | C | ||||||||
| A1/A2 | C | C | |||||||
| A1/A3 | C | C | |||||||
| A2/A1 | C | C | |||||||
| A2/A2 | C | ||||||||
| A2/A3 | C | C | |||||||
| A3/A1 | C | C | |||||||
| A3/A2 | C | C | |||||||
| A3/A3 | C |
Publisher’s Note: MDPI stays neutral with regard to jurisdictional claims in published maps and institutional affiliations. |
© 2021 by the authors. Licensee MDPI, Basel, Switzerland. This article is an open access article distributed under the terms and conditions of the Creative Commons Attribution (CC BY) license (https://creativecommons.org/licenses/by/4.0/).
Share and Cite
Auxier, B.; Scholtmeijer, K.; van Peer, A.F.; Baars, J.J.P.; Debets, A.J.M.; Aanen, D.K. Cytoplasmic Mixing, Not Nuclear Coexistence, Can Explain Somatic Incompatibility in Basidiomycetes. Microorganisms 2021, 9, 1248. https://doi.org/10.3390/microorganisms9061248
Auxier B, Scholtmeijer K, van Peer AF, Baars JJP, Debets AJM, Aanen DK. Cytoplasmic Mixing, Not Nuclear Coexistence, Can Explain Somatic Incompatibility in Basidiomycetes. Microorganisms. 2021; 9(6):1248. https://doi.org/10.3390/microorganisms9061248
Chicago/Turabian StyleAuxier, Ben, Karin Scholtmeijer, Arend F. van Peer, Johan J. P. Baars, Alfons J. M. Debets, and Duur K. Aanen. 2021. "Cytoplasmic Mixing, Not Nuclear Coexistence, Can Explain Somatic Incompatibility in Basidiomycetes" Microorganisms 9, no. 6: 1248. https://doi.org/10.3390/microorganisms9061248
APA StyleAuxier, B., Scholtmeijer, K., van Peer, A. F., Baars, J. J. P., Debets, A. J. M., & Aanen, D. K. (2021). Cytoplasmic Mixing, Not Nuclear Coexistence, Can Explain Somatic Incompatibility in Basidiomycetes. Microorganisms, 9(6), 1248. https://doi.org/10.3390/microorganisms9061248

